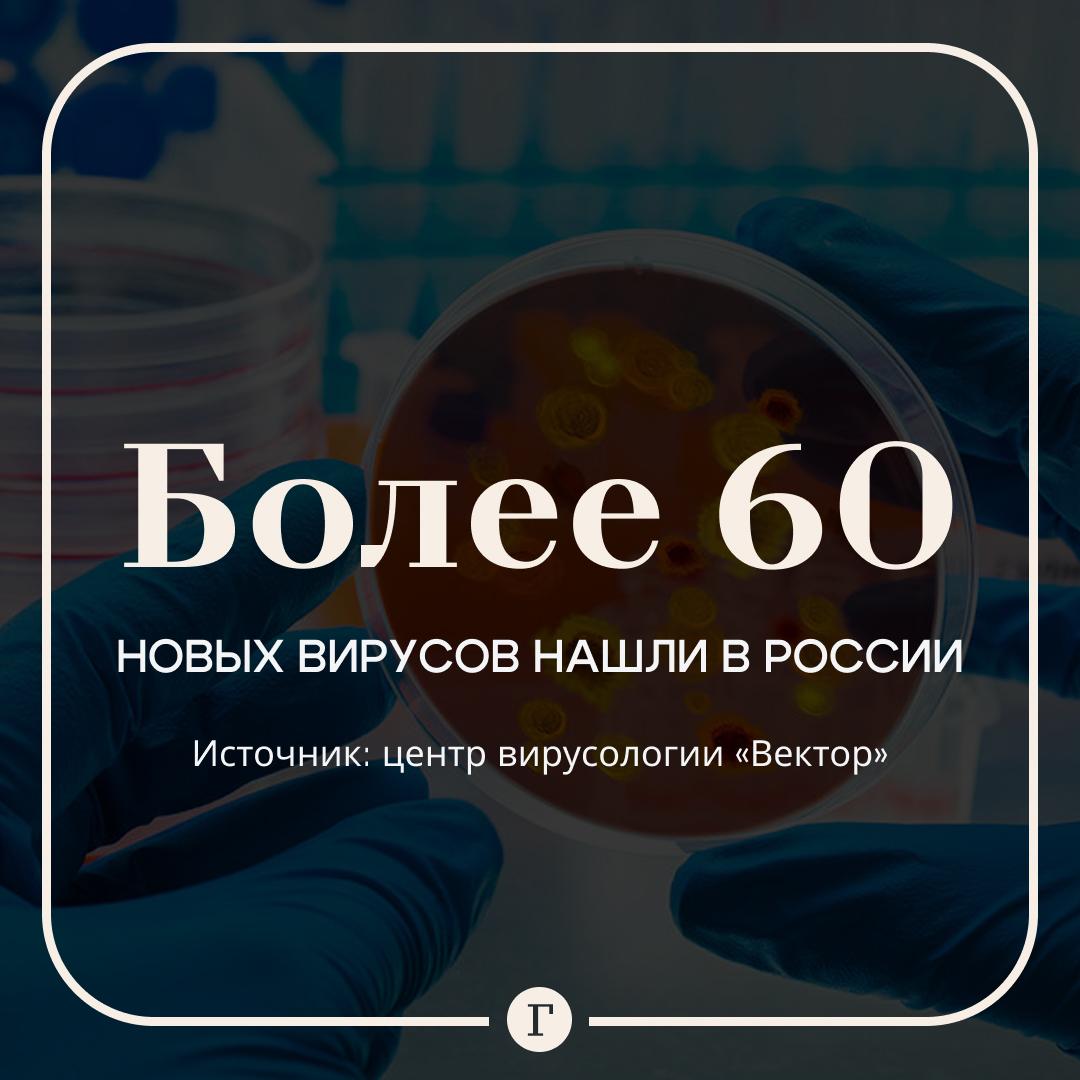
В России нашли свыше 60 новых вирусов Государственный центр вирусологии Вектор изучил образцы из более 50 регионов России и выявил десятки потенциально опасных бактерий Об этом сообщил генеральный директор Александр Агафонов Теперь ученые постараются узнать в какие заболевания могут перерасти эти вирусы какой ущерб от них грозит здоровью и заранее определить способы борьбы с ними Читайте Газету Ru в MAX Участвуйте в розыгрыше

13 ноября, 10:31
В России обнаружены более 60 неизвестных вирусов, сообщает гендиректор Вектора


Российская Газета | Новости
Государственный центр вирусологии Вектор выявил в России больше 60 вирусов которые ранее были неизвестны Об этом гендиректор центра Александр Агафонов заявил на форуме Золотая долина в Новосибирске Специалисты в рамках проекта Виром России изучали образцы из 50 регионов страны Фото Getty Images Подписаться на Российскую газету Читать нас в MAX
Общество88 дней назад

Газета.Ru
В России нашли свыше 60 новых вирусов Государственный центр вирусологии Вектор изучил образцы из более 50 регионов России и выявил десятки потенциально опасных бактерий Об этом сообщил генеральный директор Александр Агафонов Теперь ученые постараются узнать в какие заболевания могут перерасти эти вирусы какой ущерб от них грозит здоровью и заранее определить способы борьбы с ними Читайте Газету Ru в MAX Участвуйте в розыгрыше
Общество88 дней назад


Катунь 24 — новости Барнаула и Алтайского края
Более 60 неизвестных вирусов нашли учёные в России Об этом рассказал гендиректор научного центра вирусологии и биотехнологий Вектор Роспотребнадзора Александр Агафонов Для исследования учёные собрали образцы из более 50 субъектов страны Благодаря им удалось выявить более 60 неизвестных ранее вирусов Александр Агафонов уточнил что это произошло во время работы по предотвращению глобальных пандемий Он пояснил что специалисты отобрали несколько вирусов и изучили их биологическое свойство Сейчас ученые пытаются выяснить насколько опасны могут быть выявленные штаммы пишет РИА Новости Фото freepik
Общество88 дней назад


Коммерсантъ Сибирь
Более 60 ранее неизвестных вирусов выявили эксперты консорциума институтов Роспотребнадзора среди которых расположенный в Новосибирске ГНЦ Вектор Всего ими были изучены образцы из 50 регионов России сообщил во время выступления на научно производственном форуме Золотая долина гендиректор центра Вектор Александр Агафонов Влад Некрасов Коммерсантъ Подписывайтесь на Ъ Сибирь
Общество88 дней назад

Говорит Москва
Центр Вектор сообщил о выявлении более 60 новых вирусов Их предоставили 50 регионов страны Изучена генетическая структура ранее неизвестных вирусов отметил гендиректор учреждения Александр Агафонов В дальнейших планах учёных понять насколько эволюция этих вирусов будет стремительной во что она перерастёт и приведёт ли это к появлению штамма с пандемическими свойствами Агафонов пояснил что цель учёных в том чтобы предсказать чем человек будет болеть какой ущерб это заболевание может нанести и как с этим бороться Подписаться на Говорит Москва Telegram VK MAX
Общество88 дней назад

Сноб — Новости
Учёные нашли в России более 60 новых вирусов Образцы собрали в 50 регионах специалисты изучают их генетическую структуру и биологические свойства
Общество88 дней назад


РБК. Новости и главное
В России обнаружили более 60 ранее неизвестных вирусов Их нашли по результатам изучения образцов из 50 регионов страны сообщил центр вирусологии Вектор Теперь специалистам предстоит изучить насколько стремительной будет эволюция этих вирусов а также приведут ли они к появлению штамма с пандемическими свойствами Для нас очень важно найти не только те вирусы которые есть но и особенно важно найти именно патогенные для человека вирусы сказал гендиректор центра Александр Агафонов Он считает что для прогнозирования структуры лекарств и новых вакцин нужно использовать искусственный интеллект Фото Chokniti Khongchum Pexels Подписаться на РБК Life
Общество88 дней назад


Sakh.online - новости Сахалина и Курил
Более 60 новых вирусов обнаружили в России Открытие ссовершили специалисты центра вирусологии Вектор Это результат масштабного исследования в ходе которого были изучены образцы собранные в 50 регионах страны Теперь перед учеными стоит задача определить потенциальную опасность найденных патогенов Им предстоит изучить скорость эволюции вирусов и оценить способны ли они привести к появлению штамма с пандемическими свойствами Подписаться на нас Telegram I MAX Прислать нам новость Sakhonlinebot
Общество88 дней назад
Похожие новости



+6



+12



+27



+9



+4



+25

Штамм XFG Stratus остается доминирующим в новых случаях COVID-19 в России
Происшествия
21 час назад


+6
В Реутове введен карантин по бешенству после выявления случая заболевания
Наука
1 день назад


+12
Российская вакцина от аллергии на пыльцу берёзы ожидает регистрации в 2026 году
Наука
13 часов назад


+27
В Москве и Новосибирске обсуждают развитие образования и науки
Общество
1 день назад


+9
Обсуждение развития гражданских БАС и поддержка молодых ученых на форуме Дронтех
Общество
1 день назад


+4
Обновление пассажирских поездов и поздравление ученых Херсонщины с Днем науки
Общество
1 день назад


+25